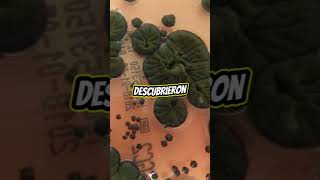
Hay un hongo en Chernobyl…que se alimenta de radiación.Sí… leíste bien #casosreales

- Популярные видео
- Авто
- Видео-блоги
- ДТП, аварии
- Для маленьких
- Еда, напитки
- Животные
- Закон и право
- Знаменитости
- Игры
- Искусство
- Комедии
- Красота, мода
- Кулинария, рецепты
- Люди
- Мото
- Музыка
- Мультфильмы
- Наука, технологии
- Новости
- Образование
- Политика
- Праздники
- Приколы
- Природа
- Происшествия
- Путешествия
- Развлечения
- Ржач
- Семья
- Сериалы
- Спорт
- Стиль жизни
- ТВ передачи
- Танцы
- Технологии
- Товары
- Ужасы
- Фильмы
- Шоу-бизнес
- Юмор
Видео Youtube, Radiacion
5 ч. 40 мин. назад The emergency channel Жалоба на материал Недопустимый материал Нарушение авторских прав
21 ч. 31 мин. назад Luigi Skeleton Жалоба на материал Недопустимый материал Нарушение авторских прав
22 апреля 2026 г. 23:57:04 RADIO CANELA Жалоба на материал Недопустимый материал Нарушение авторских прав
22 апреля 2026 г. 21:06:09 RADIO CANELA Жалоба на материал Недопустимый материал Нарушение авторских прав
22 апреля 2026 г. 20:02:41 La Mente Geek Жалоба на материал Недопустимый материал Нарушение авторских прав
22 апреля 2026 г. 12:20:51 ¿Quien anda ahí? Podcast Жалоба на материал Недопустимый материал Нарушение авторских прав
22 апреля 2026 г. 11:26:36 Yo Estuve ahí - Eventos y Misterios del pasado Жалоба на материал Недопустимый материал Нарушение авторских прав
22 апреля 2026 г. 9:21:36 Creativos RP Жалоба на материал Недопустимый материал Нарушение авторских прав
22 апреля 2026 г. 9:04:01 Creativos RP Жалоба на материал Недопустимый материал Нарушение авторских прав
22 апреля 2026 г. 9:00:18 👉Snape lo sabe👈 Жалоба на материал Недопустимый материал Нарушение авторских прав
22 апреля 2026 г. 8:52:29 👉Snape lo sabe👈 Жалоба на материал Недопустимый материал Нарушение авторских прав
22 апреля 2026 г. 8:48:05 RADIO CANELA Жалоба на материал Недопустимый материал Нарушение авторских прав
22 апреля 2026 г. 5:00:23 Yolo Camotes Жалоба на материал Недопустимый материал Нарушение авторских прав
20 апреля 2026 г. 19:01:18 Lily Loudster Жалоба на материал Недопустимый материал Нарушение авторских прав
18 апреля 2026 г. 3:56:30 👉Snape lo sabe👈 Жалоба на материал Недопустимый материал Нарушение авторских прав
18 апреля 2026 г. 3:55:16 👉Snape lo sabe👈 Жалоба на материал Недопустимый материал Нарушение авторских прав
18 апреля 2026 г. 0:15:11 Curiosiraptor Жалоба на материал Недопустимый материал Нарушение авторских прав
17 апреля 2026 г. 23:47:15 RADIO CANELA Жалоба на материал Недопустимый материал Нарушение авторских прав
17 апреля 2026 г. 21:00:31 Doctora Pozo Жалоба на материал Недопустимый материал Нарушение авторских прав
17 апреля 2026 г. 15:00:13 Grupo REFORMA Жалоба на материал Недопустимый материал Нарушение авторских прав
17 апреля 2026 г. 5:21:33 El Judini Жалоба на материал Недопустимый материал Нарушение авторских прав
17 апреля 2026 г. 1:40:42 Imagen Noticias Жалоба на материал Недопустимый материал Нарушение авторских прав
16 апреля 2026 г. 22:00:06 Telediario Monterrey Жалоба на материал Недопустимый материал Нарушение авторских прав
16 апреля 2026 г. 18:10:10 Imagen Noticias Жалоба на материал Недопустимый материал Нарушение авторских прав
15 апреля 2026 г. 7:54:47 Gael Teran Жалоба на материал Недопустимый материал Нарушение авторских прав
14 апреля 2026 г. 21:20:53 lavigiliadelumbral Жалоба на материал Недопустимый материал Нарушение авторских прав
14 апреля 2026 г. 16:40:32 Historias que Impactan Жалоба на материал Недопустимый материал Нарушение авторских прав
La radiación no se contagia. Una persona se contamina con un elemento radiactivo, pero no se contagi
14 апреля 2026 г. 0:30:27 entreradiologos Жалоба на материал Недопустимый материал Нарушение авторских прав